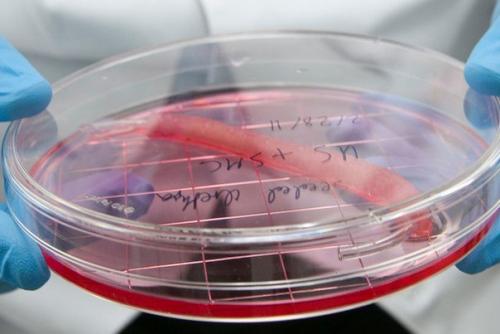
Все, что Могло Быть Изобретено, уже Изобрели,  - заявил уважаемый эксперт из британского бюро патентов в 1899 году. 04

"Все, что Могло Быть Изобретено, уже Изобрели, " - заявил уважаемый эксперт из британского бюро патентов в 1899 году.
Выращивание органов, редактирование генов, искусственная матка и планета, подходящая для переселения человечества - это краткий список открытий 2017 года. А год еще не окончен.
2017 год приблизил мир к научно-фантастическому будущему, начиная с регенерации человеческих клеток для выращивания органов и заканчивая созданием 51-кубитного квантового компьютера - и это год еще не закончился. Futurism огласил список из 10 самых значимых открытий за последние 8 месяцев.

1. "Отредактирован" человеческий эмбрион.

27 июля в Портленде, штат Орегон, ученые добились значительного прорыва в технологии генного редактирования. Воспользовавшись Crispr, они успешно удалили у человеческого эмбриона ген, связанный с сердечными заболеваниями.

2. создан металлический водород.

27 января впервые в науке ученые создали металлический водород, применив почти пять миллионов атмосфер давления к жидкому водороду. В своем металлическом состоянии водород может действовать как настоящий сверхпроводник, технология совершит революцию во многих областях - от хранения энергии до ракетостроения.
3. обнаружена планета, на которой можно жить.

19 апреля ученые из европейской организации астрономических исследований нашли лучшую планету для внеземной жизни. LHS 1140b была обнаружена в обитаемой зоне тусклой звезды в 40 световых годах от земли.

4. Crispr отредактировал гены внутри человеческого тела.

1 июня ученые впервые применили технологию генного редактирования Crispr (наиболее доступную технику редактирования генов) в человеческом теле. Новое исследование было направлено на удаление вируса папилломы человека (ВПЧ) у 60 женщин, путем применения геля, содержащего необходимое кодирование днк для шейки матки, чтобы отключить механизм роста опухоли.

5. новые технологии позволят выращивать органы.

1 мая были сделаны успехи в области регенеративной медицины. Институт регенеративной медицины Wake Forest в настоящее время возглавляет проекты по выращиванию человеческих органов и тканей. Открытия его исследователей могут помочь в восстановлении повреждений нервов и даже вырастить целые конечности и внутренние органы.
6. Google научил ИИ адаптироваться к сложной среде.
11 июля подразделение Google по искусственному интеллекту Deepmind опубликовало статью, иллюстрирующую, как его специалисты обучают ИИ - алгоритмы адаптироваться к сложной и меняющейся среде.
7. Spacex повторно запустила "Отработанную" ракету.
30 марта Spacex успешно запустила на орбиту и посадила уже использовавшийся ракетоноситель Falcon 9. этот прорыв еще больше увеличил доступность космических запусков - экономия более $18 млн за каждый пуск.
8. создана искусственная матка.
26 апреля врачи детской больницы филадельфии сумели сымитировать женскую матку с использованием синтетического устройства для предотвращения смертности и болезней преждевременно рожденных детей младше 37 недель, эксперимент был проведен на новорожденном ягненке.
9. новый прорыв в квантовых вычислениях.
28 июля на международной конференции по квантовым технологиям в Москве был представлен рекордный 51-кубитный квантовый компьютер, открывающий путь для новых применений технологии.
10. ИИ Alphago доказал превосходство над людьми в игре го.
29 мая ИИ от компании Deepmind (принадлежит Google) обыграл пять лучших в мире игроков в го. Впервые он человека в прошлом году обыграл.
"ИТ - Компаниям Нужны Гуманитарии, а не Stem - Специалисты".
Больших успехов также удалось достичь в создании клеточного "Эликсира Молодости". Два независимых открытия были совершены генетиками: в первом случае замедлить старение позволяет ген Nanog, который изучали в университете Баффало, а во втором внимание ученых бразильского фонда научных исследований привлек фермент теломераза.